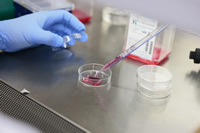

順天堂大学 薬学部
| 住所 | 〒279-0013 千葉県浦安市日の出6-8-1(浦安・日の出キャンパス) |
|---|---|
| Tel | 047-354-3311 |
| URL | https://www.juntendo.ac.jp/academics/faculty/pha/ |
順天堂大学は薬学部を開設します

本学は1838年江戸薬研堀に開設された医学塾を始まりとし、「仁」を学是としています。「仁」とは、他を思いやり慈しむ心です。本学では、病める人や健康な人の身体のみならず心も理解して医療、健康・福祉が実践できる人材を育成する全人教育を開学以来2世紀近く行っています。本学に設立する薬学部においても、医学部や医療看護学部などの他学部と密接に連携し、グローバル社会の中で病める人や健康な人に適切な医薬品や健康機能性素材等を使用できる薬剤師や、社会の要請に合った医薬品や健康機能性素材を開発できる研究者の育成を目指します。
健康総合大学でできる多職種連携
本学は、医学部をはじめとし、現在8学部を有する健康総合大学です。
医師・看護師だけでなく多方面で医療人として活躍できる学生が学んでいます。新たに生まれる薬学部では他学部の学生とともに学び、チーム医療の中で職能を発揮できる力がつきます。特に医学部・医療看護学部と連携した教育により、健康な状態から病める状態を理解し、それらに応じた薬物治療を系統的に学び、多彩な臨床現場を経験することで、臨床実践力がつきます。
最先端の高度医療教育
順天堂は6つの附属病院があり、日本最大規模を誇ります。
それぞれ先進医療、救急医療、周産期医療、高齢者医療、精神医療、がん治療など特色ある機能を備えた高度先進医療を提供しています。
専門性の高い病院で、臨床経験豊富な薬剤師・教員指導の下、臨床実習が可能です。
基礎研究と臨床研究を融合させる医療薬学実践研究

1年次から先端的な研究を実践している若手教員から薬学研究の楽しさを学び、臨地実習を通じて臨床経験豊富な薬剤師・教員から臨床研究を学ぶなど、学生の希望に応じた様々な薬学研究に携わることが可能です。
浦安・日の出キャンパス
浦安地区に2022 年4月よりキャンパスを新設しました。医療科学部・健康データサイエンス学部に続き3番目の学部として開学予定です。キャンパスの整備と共に、充実した施設で学ぶことができます。新浦安はリゾートを感じさせる便利な街で、東京駅からJR 京葉線・武蔵野線快速で16~18分と都心からも近く、新浦安駅下車。「新浦安駅」C乗り場よりバス。
























